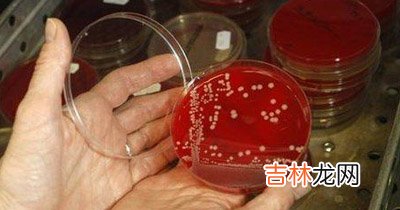

加拿大多伦多市医院,在mrsa重症病房工作的医护人员均身着隔离服 。
阿什顿·邦兹,本月4日感到身体一侧疼痛,就到当地一家医院就诊 。
北京10月18日专电 美国政府日前发布的一份关于抗药性耐甲氧西林金黄色葡萄球菌(mrsa)的报告说,据推算每年有9万多美国人染上这种可能致命的“超级病菌” 。
美联社援引公共健康专家的话说,“超级病菌”的传播已经超出了传统的医院环境 。过去它只发生在医院内,而今已经逐渐扩散到监狱、体育馆、城市周边等地方 。
mrsa可以在人体皮肤或鼻子内生存,严重情况下会感染人体血液、肌肉,甚至导致死亡 。它的整体感染率为十万分之三十二,发表报告的《美国医学会杂志》说,这是一个令人震惊的数字 。
2005年的数据表明,美国最有代表性的9个城市地区共报告了5287个感染病例,据此推算,美国全国当年约有9.436万个病例 。
根据该研究,感染者中有988人死亡 。研究者目前还没有确定mrsa是不是导致这些死亡案例的直接原因 。
由于人们滥用青霉素等抗生素,mrsa产生了抗药性,尽管现在仍有药物可以控制它,但专家担心,如果滥用的话,mrsa对现有药物也将产生抗药性 。
【美国:发现“超级病菌”MRSA】
文章插图
经验总结扩展阅读
- 这些“坏”食物更适合减肥
- 流通生猪将一律佩戴“身份证”
- 调查显示上海女白领最不爱下厨 嫌“做饭麻烦”
- 睡眠研究发现:鱼类也会赖床也失眠
- 一男子天生“阴阳脸” 手术变脸开始新人生
- 流感疫苗接种已正式启动 流感疫苗无法包治“感冒”
- 专家称喜马拉雅“野人”疑为野生动物
- 英国政府医院牙医少 病患“铤而走险”自己拔牙
- 英科学家研究发现过度肥胖减寿13年
- 糖尿病合并冠心病有“四害”
